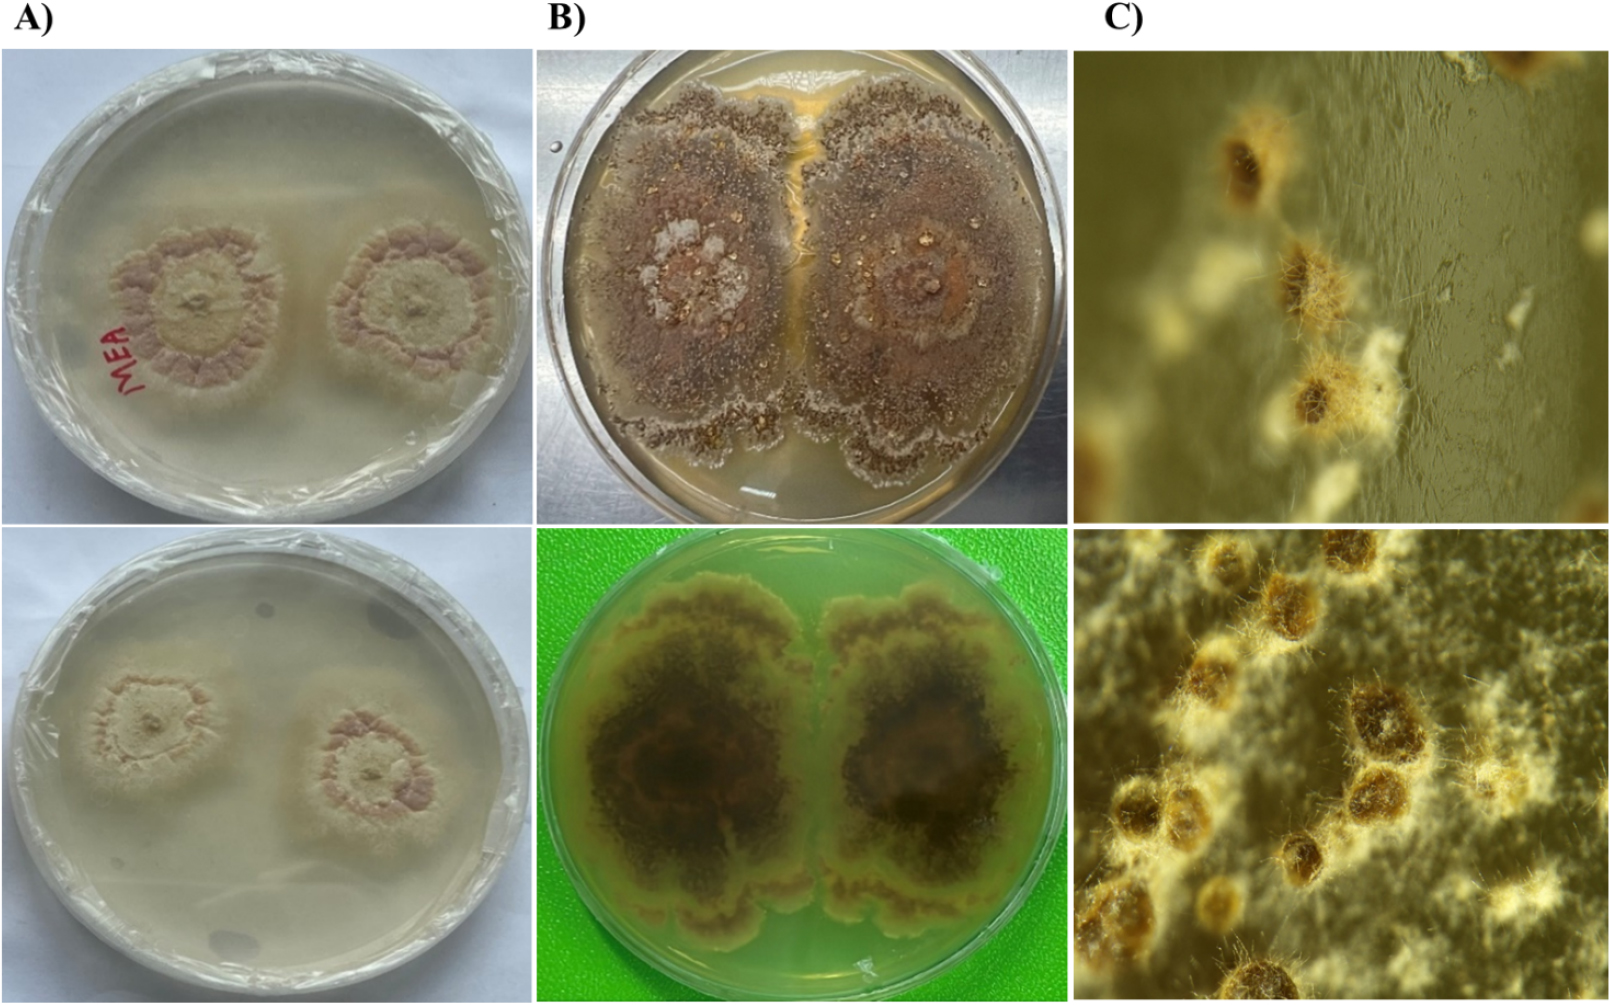
https://cdn.apub.kr/journalsite/sites/ktappi/2025-057-06/N0460570608/images/ktappi_2025_576_94_F4.jpg

1. Introduction
2. Materials and Methods
2.1 Paper pulp sample collection
2.2 Isolation and microscopic characterization
2.3 Genomic DNA extraction, sequencing, and data analysis
3. Results and Discussion
3.1 Physical and mechanical properties of pulp sheets and microscopic observation
3.2 Morphological characteristics of Thermoascus crustaceus
3.3 Molecular phylogeny of Thermoascus crustaceus
4. Conclusions
1. Introduction
The genus Thermoascus comprises thermophilic cleistothecial fungi of the family Thermoascaceae (order Eurotiales, class Eurotiomycetes, phylum Ascomycota). First described by Hugo Miehe with Thermoascus aurantiacus as the type species, members of this genus are adapted to high-temperature environments such as soil, compost, and decaying organic matter [1,2]. They produce superficial red-brown ascomata with variable morphologies. Thermoascus species are noted for forming heat-resistant ascospores and secreting thermostable hydrolases, including cellulases and xylanases. These enzyme secretions enable their lignocellulose degradation characters that emphasize their biotechnological value in biomass conversion and industrial enzyme production.
Thermophilic fungi have been extensively studied for their roles in organic matter decomposition and enzyme secretion [3], however reports of their occurrence in industrial materials such as hardwood pulp remain limited. In general, pulp production in paper making company usually occurs under high temperature (> 45°C) conditions which is more suitable for the survival of thermophilic fungi. Despite sterilizing effects of steaming and bleaching, residual species can persist and proliferate during storage condition under higher moist specially during summer season. This localized rise in temperature and humidity makes favorable conditions for fungal growth, which is predominantly observed at the interior portions of the bundles. Their cellulolytic and hemicellulolytic activities may degrade pulp fibers, leading to discoloration, surface spotting, and reduced mechanical strength, thereby compromising paper quality and increasing chemical demands during bleaching issues of both economic and environmental concern.
In this study, we isolated and characterized a thermophilic ascomycete from discolored commercialized hardwood pulp sheets in Korea. Biodeterioration in commercial hardwood pulp reveals as reddish-brown spots, surface discoloration, and material loss caused by enzymatic degradation and fungal activity. Morphological, and molecular (28S rRNA gene) analyses identified the isolate as T. crustaceus. This study provides not only the first record of T. crustaceus isolated from hardwood pulp but also establishes the first confirmed record of this species, having teleomorph and anamorphic stage observation in Korea, thereby broadening the known ecological and geographical range of the genus, highlighting its potential role in pulp deterioration under high-temperature industrial conditions.
2. Materials and Methods
2.1 Paper pulp sample collection
Dried hardwood pulp sheets as a raw material obtained from the storage of a paper manufacturing company in Korea. The pulp was made by mechanical method. It has been used for commercial purpose of paper making and during the summer season storage the fungal contamination was noticed. Therefore, all samples were obtained by the Laboratory of Jeonbuk National University and subsequently inspected for symptoms of fungal deterioration in July 2025 from the storage of large pulp sheet bundles. All the sample kept under 4°C. Each sample was carefully examined under a stereomicroscope (Carl Zeiss, Oberkochen, Germany) to assess the overall paper condition, degree of discoloration, and presence of radish brown dot spots (size is > 0.5 mm) or visible fungal spores. Fungal materials were aseptically collected by gently scraping visibly damaged brown areas using sterile scalpel blades. Additionally, small paper fragments and fibers, particularly from the edges of deteriorated regions, were collected with sterile tweezers and transferred to sterile containers for further microbiological analysis [4]. The physical property of pulp sheet was measured.
2.2 Isolation and microscopic characterization
The initial isolation of fungi was carried out on potato dextrose agar (PDA; MB Cell, Los Angeles, CA, USA) medium. Fungal isolation was performed using a culture-dependent approach on PDA supplemented with 0.2 g/L chloramphenicol to suppress bacterial growth. Plates were incubated at various temperatures ranging from 25 to 55°C to determine the optimal growth temperature. The isolate was initially grown at 50°C and sub-cultured repeatedly until pure cultures were obtained. Morphological characteristics of the fungal isolate LEEJBNU-25 were examined on PDA, and malt extract agar (MEA; Difco, USA) following standard procedures for fungal culture characterization [1,5]. Additionally, colonies cultivated on PDA at 55°C were monitored for morphological development and sporulation over a 14-day period. Observations focused on colony texture, pigmentation, margin characteristics, and sporulation patterns, in accordance with established taxonomic criteria [1,5,6]. Macroscopic morphology of fungal isolates was captured for observing the colony morphology, surface, edge and color. The microscopic image was taken for mycelia, ascospores, and conidia were observed with Zeiss AX10 microscope equipped with an AxioCam MRc5 camera (Carl Zeiss, Oberkochen, Germany) light microscope. The JEOL (JSM-5900) scanning electron microscope (SEM) was used from Jeonbuk National university CURF facility center.
2.3 Genomic DNA extraction, sequencing, and data analysis
Genomic DNA of the isolated fungal strains was extracted using the AllPrep Bacterial DNA/RNA/Protein Kit (Qiagen, Germany) following the manufacturer’s protocol. The D1-D2 variable region of the nuclear large subunit (LSU) ribosomal RNA gene, considered informative for fungal phylogenetic analysis [7,8]. It was amplified by polymerase chain reaction (PCR) using the universal primers NL1 (5′-GCATATCAATAAGCGGAGGAAAAG-3′) and NL4 (5′-GGTCCGTGTTTCAAGACGG-3′) [9]. PCR was performed in a total reaction volume of 50 µL containing 10 mM Tris-HCl (pH 8.3), 50 mM KCl, 1.5 mM MgCl2, 0.8 mM deoxynucleoside triphosphates (0.2 mM each), 1.2 U of Taq DNA polymerase, 0.4 µM each primers and 2 µL (1 to 5 ng) of DNA template. PCR amplification was performed using the following thermal cycling conditions: an initial denaturation at 95°C for 10 minutes; followed by 30 cycles of denaturation at 94°C for 40 second, annealing at 60°C for 40 second, and extension at 72°C for 1 minute; with a final extension at 72°C for 3 minutes. A non-purified PCR product at a concentration of 50 ng/µL was submitted to the company for subsequent analyses. The PCR products were purified and sequenced by Bionics (Daejeon, Korea). The sequencing result of D1-D2 region of the large-subunit rRNA gene was analyzed. The generated nucleotide sequences were proofread and compared to those in the GenBank database using a BLAST search. The top ten similarity reference strains were used for phylogenetic analysis and compared to determine the phylogenetic relationship with the reference strain of previously published Thermoascus species. The phylogenetic tree with reference strains by neighbor-joining method was constructed using MEGA 11 (TreeView software) [10].
3. Results and Discussion
3.1 Physical and mechanical properties of pulp sheets and microscopic observation
Photomicrographs of hardwood pulp sheets morphological structures exhibited visible discoloration, reddish-brown spots, fragments, and small holes, all typical symptoms of bio-deterioration induced by fungal growth. The physical and mechanical characteristic of our sample was provided in Table 1. Dimensions of each sheet (31 × 31 cm) average basis weight was 61.48 g/m2 and the average thickness was 158.71 µm. Generally, the relative humidity within the storage facility of large pulp sheet bundles is typically maintained at approximately 7%. However, during the summer months, both temperature and humidity levels can increase substantially, reaching up to 30% in the central region of large bundles of pulp sheets.
Table 1.
Summary of physical and mechanical characteristics of pulp sheets sample
The reddish-brown spots and uneven texture suggest enzymatic degradation and pigment deposition by fungal hyphae and ascospores, leading to weakening and fragmentation of paper fibers (Fig. 1A–C). The stereo microscopic result showed a 3D mycelial proliferation at anamorphic stage on PDA plate (Fig. 1D–E). The dense hyphal mats and spore-like structures confirming fungal sporulation. Further, it reveals the radial filament arrangement indicates active surface and subsurface colonization. The SEM shows the maturing hyphae and emerging ascospores form and the fungal structure integrated with hardwood pulp matrix (Fig. 2). The close-up image shows the prolific, densely packed ascospores (spore chains typical of Thermoascus species) covering the pulp surfaces and ascospores with surface verrucose ornaments (Fig. 2B–C).

Fig. 2.
SEM analysis. (A) Untreated hardwood pulp showing intact, smooth cellulose fibers with well-defined fibrillar structure. (B) Initial fungal colonization visible as clusters of ascospores and hyphae adhering to the paper fiber surface. (C, D) Extensive fungal proliferation and ascospores structures distributed along the surface. (E) High-magnification image showing densely packed ascospores with ornamented or roughened surfaces, characteristic of mature sporulation structures. (F) Enlarged view of an individual ascospore with a textured outer surface and distinct wall pattern, confirming morphological differentiation during spore maturation. Ascospore with concavity (red arrow).
3.2 Morphological characteristics of Thermoascus crustaceus
In our study, the light microscopic identification showed morphologies of ascospores, conidia and related structures. These morphologies correspond to both teleomorphic stage taken from hardwood pulp sheets and anamorphic stages of the fungus from plate, as described for T. crustaceus and its anamorph, Paecilomyces crustaceus[1]. In the current study, the fungal isolate was identified later as T. crustaceus.
GeneBank accession No: PX458021
Taxonomy
Thermoascus crustaceus (Apinis and Chesters) Stolk, 1965 [11].
= Dactylomyces crustaceus Apinis and Chesters, 1964 [12].
Typus: This strain was isolated in July 2025 from a dried hardwood pulp sheet used for commercial paper making purpose in paper mills, collected from Daegu, South Korea by Department of Wood Science and Technology, College of Agriculture and Life Sciences, Jeonbuk National University.
Description: Ascomata not seen. Ascospores of T. crustaceus were as oval, ornamented spores, some clustered together and having verrucose (warty) surface (Fig. 3A). The arrangement was ellipsoidal, verrucose, and thick-walled. Asci were typically globose to subglobose, 8-spored, had a slightly extruded germ slit and was short. These are transient structures in the sexual reproductive phase (Fig. 2).
Conidiophore not observed. The filamentous stipes which are hyphal threads, demonstrating the extensive spread of basal mycelia. Various types of conidia including globose, oval to ellipsoidal to cylindrical, apices rounded (obtuse). Small cylindrical conidia size approximately 1.3 - 1.6 µm in length. Outer layer consisting of light yellow, thick walled. others are globose to subglobose, all less or more thick-walled, cylindrical ordered chains, round conidia thick walled with size 4.2 - 5.1 µm, elongated trenched at both ends measuring size of 5.3 - 6.1 µm. Some conidia have specialized wall structure of concavity, oil droplet within conidia (Fig. 3I). Further, our SEM result described the provides high-resolution surface detail of these ascospores, revealing dense verrucose ornamentation and a textured, rough surface. The measuring size as seen under light microscopy, but highlights additional fine-scale ornamentation and the external architecture that is not distinguishable in the light micrograph, was seen in SEM. Ascospores were same clustered, ellipsoidal form, ascospores has concavity.
Colonies on MEA grew moderately, reaching about 12 - 15 mm in diameter after 14 days at 45°C (Fig. 4). The colony surface on MEA medium was floccose to velvety with distinct concentric ring like pattern and a pale cream center and light pink outer margin mycelia. The reverse side appeared cream to yellowish, and mycelia were dense and well-developed. Besides on the PDA medium, the colonies reached a diameter of 20 - 22 mm. It appeared dark brown and wrinkled, with a compact and leathery texture. The center was darker and more elevated, while the margin was irregular. The reverse showed a deep brown pigmentation, suggesting possibly strong secondary metabolite or pigment production. The colony grew faster than MEA medium and showed a powdery to granular texture with abundant aerial mycelia. The surface color changed from pale yellow to brownish-orange. The reverse was dark yellow to amber (Fig. 4).
Fig. 4.
Colony morphology of the isolated thermophilic fungus on different culture media. (A) Growth on malt extract agar (MEA) showing floccose, pale pinkish-white colonies with concentric rings; (B) colony on potato dextrose agar (PDA) showing dark brown, compact, and wrinkled colonies. Upper and lower panels represent front and reverse sides of the corresponding cultures, respectively. (C) Stereomicroscopy revealed three-dimensional filamentous (side view and top view) growth with dense mycelial mats and spore-like structures of colony from plate.
Our result was in agreement with previous study where they found T. crustaceus from soil sample in Japan [1]. However, we could not find the ascomata in teleomorph stage. Hypothetically, Ascomata autolysis happened because fungal fruiting body, having completed spore formation, activates self-degrading enzymes to release spores and recycle cellular nutrients. Overall, the fungus displayed a thermotolerant and filamentous growth pattern [5]. Further, it showed dense aerial hyphae, pigmented mycelium, and exudate formation on rich media. Additionally, when the fungus was grown at different temperatures, it showed a reasonable growth rate even at higher temperatures. Similar distinctive features were described for thermophilic fungi in previous studies [5]. A recent report has described the identification of Thermoascus species which has similar morphological characteristics from our result, isolated from clinical samples obtained from hospital patients [3,13]. However, in this study, the fungus was specifically isolated from a hardwood pulp sheet. Specimen examined: LEEJBNU25-10, in dried culture isolated from dried hardwood pulp sheet, Daegu, South Korea, in July 2025, Y. Lee.
3.3 Molecular phylogeny of Thermoascus crustaceus
To determines the evolutionary status, the sequences of D1-D2 region of the isolates were aligned for phylogenetic analysis against references. Our isolated strains showed 100% identity with JF922031.1, FJ358289.1, and EU021597.1 reference strains (Fig. 5A). It was identified as Thermoascus species (Fig. 5B). The isolate was more close to T.crustaceus which confirms it belongs to same fungus. Thermoascuscrustaceus is a heat-resistant fungus commonly found in compost, soil, air, and stored grains, and can be inhaled by humans. Because it grows well above mammalian body temperatures [3,13], further research on its thermotolerance and molecular characteristics is needed to assess its pathogenic potential.
4. Conclusions
This study signifies the identification and characterization of fungus accountable for the dark radish-brown spot observed on hardwood pulp sheets during summer storage. To our knowledge, this is the first documented case of T. crustaceus infection in hardwood pulp. It demonstrated robust growth at temperatures up to 55°C, with optimal growth near 50°C, confirming its thermophilic nature. However, the pathway of fungal contamination remains unknown, whether it initiated from the raw materials, manufacturing process, or during storage environment. In addition, the extent of fiber damage causede by the fungus has not been evaluated. Future research will aim to clarify the source and to develop effective approaches for preventing fungal growth in hardwood pulp sheets.





